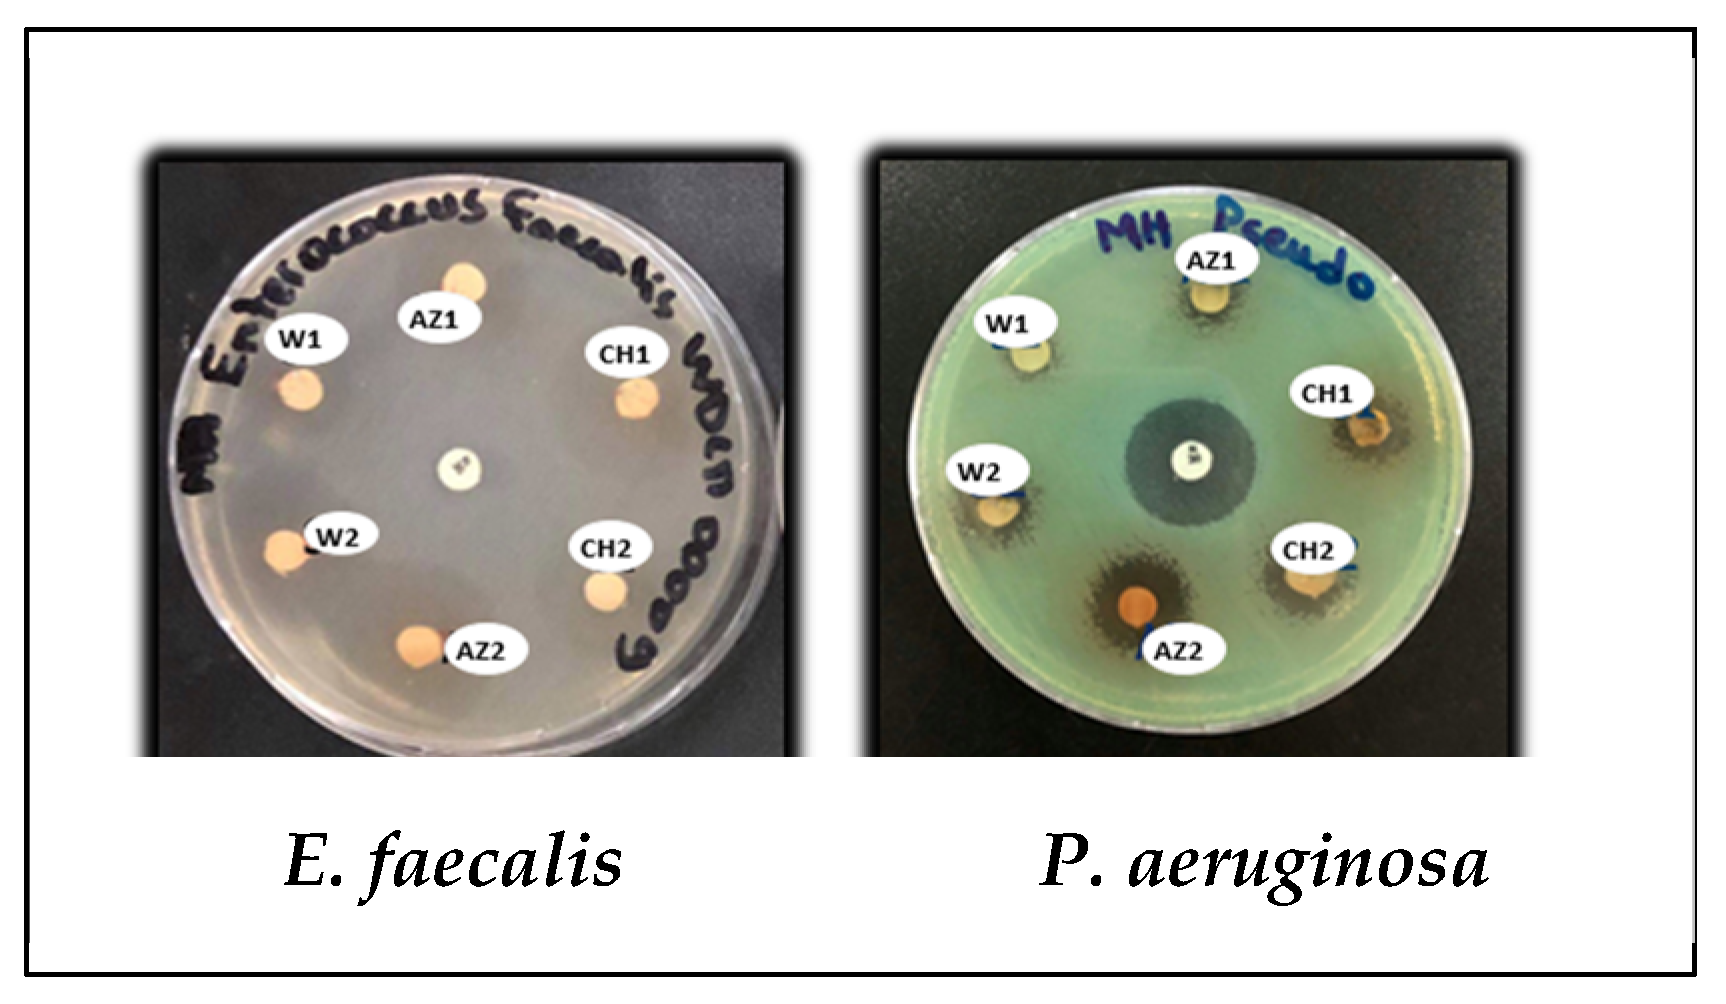
Processes 13 00559 g005

Olive Tree Twigs as an Attractive Green Source of Antioxidant and Antibiofilm Biomolecules
Abstract
1. Introduction
2. Materials and Methods
2.1. Sample Collection
2.2. Polyphenol Recovery and Quantification
2.3. DPPH Radical Scavenging Activity
2.4. Antimicrobial Activity Tests
2.4.1. Microorganisms Strains Used for Testing
2.4.2. Antimicrobial Susceptibility Using the Disk Diffusion Method
2.4.3. Minimal Inhibitory Concentrations
2.4.4. Antimicrobial Activity Using the Viability Testing Method
2.4.5. Antibiofilm Testing
Biofilm Formation Assay
Antibiofilm Activity Testing Using a Crystal Violet Assay
2.5. Data Analysis
3. Results
3.1. Polyphenol Yield and Content
3.2. Antioxidant Activity
3.3. Antibacterial Susceptibility Testing
3.3.1. Disk Diffusion Method
3.3.2. Determination of MICs
3.3.3. Bactericidal Activity (Viability Testing)
3.4. Antibiofilm Action
3.4.1. Biofilm Formation Potential
3.4.2. Olive Tree Twig Antibiofilm Potential
4. Discussion
5. Conclusions
Author Contributions
Funding
Data Availability Statement
Acknowledgments
Conflicts of Interest
References
- Carrascosa, C.; Raheem, D.; Ramos, F.; Saraiva, A.; Raposo, A. Microbial Biofilms in the Food Industry—A Comprehensive Review. Int. J. Environ. Res. Public Health 2021, 18, 2014. [Google Scholar] [CrossRef] [PubMed]
- Francolini, I.; Donelli, G. Prevention and control of biofilm-based medical-device-related infections. FEMS Immunol. Med. Microbiol. 2010, 59, 227–238. [Google Scholar] [CrossRef] [PubMed]
- Elafify, M.; Liao, X.; Feng, J.; Ahn, J.; Ding, T. Biofilm formation in food industries: Challenges and control strategies for food safety. Food Res. Int. 2024, 190, 114650. [Google Scholar] [CrossRef]
- LaPointe, G.; Wilson, T.; Tarrah, A.; Gagnon, M.; Roy, D. Biofilm dairy foods review: Microbial Community Tracking from Dairy Farm to Factory: Insights on Biofilm Management for Enhanced Food Safety and Quality. J. Dairy Sci. 2024; in press. [Google Scholar] [CrossRef]
- Zafer, M.M.; Mohamed, G.A.; Ibrahim, S.R.M.; Ghosh, S.; Bornman, C.; Elfaky, M.A. Biofilm-mediated infections by multidrug-resistant microbes: A comprehensive exploration and forward perspectives. Arch. Microbiol. 2024, 14, 101. [Google Scholar] [CrossRef]
- Bakkiyaraj, D.; Nandhini, J.R.; Malathy, B.; Pandian, S.K. The anti-biofilm potential of pomegranate (Punica granatum L.) extract against human bacterial and fungal pathogens. Biofouling 2013, 29, 929–937. [Google Scholar] [CrossRef]
- Slobodníková, L.; Fialová, S.; Rendeková, K.; Kováč, J.; Mučaji, P. Antibiofilm activity of plant polyphenols. Molecules 2016, 21, 1717. [Google Scholar] [CrossRef]
- Li, J.; Du, C.; Liu, Z.; Li, X. Electrochemical studies of microbiologically influenced corrosion of X80 steel by nitrate-reducing Bacillus licheniformis under anaerobic conditions. J. Mater. Sci. Technol. 2022, 118, 208–217. [Google Scholar] [CrossRef]
- Yin, W.; Xu, S.; Wang, Y.; Zhang, Y.; Chou, S.H.; Galperin, M.Y.; He, J. Ways to control harmful biofilms: Prevention, inhibition, and eradication. Crit. Rev. Microbiol. 2021, 47, 57–78. [Google Scholar] [CrossRef]
- Shi, J.; Xu, J.; Liu, X.; Goda, A.; Salem, S.H.; Deabes, M.M.; Ibrahim, M.I.M.; Naguib, K.; Mohamed, S.R. Evaluation of some artificial food preservatives and natural plant extracts as antimicrobial agents for safety. Discov. Food 2024, 4, 89. [Google Scholar] [CrossRef]
- Saleh, E.; Morshdy, A.E.; El-Manakhly, E.; Al-Rashed, S.; Hetta, H.F.; Jeandet, P.; Yahia, R.; El-Saber Batiha, G.; Ali, E. Effects of Olive Leaf Extracts as Natural Preservative on Retailed Poultry Meat Quality. Foods 2020, 9, 1017. [Google Scholar] [CrossRef] [PubMed]
- Munekata, P.E.S.; Pateiro, M.; Bellucci, E.R.B.; Domínguez, R.; da Silva Barretto, A.C.; Lorenzo, J.M. Strategies to increase the shelf life of meat and meat products with phenolic compounds. Adv. Food Nutr. Res. 2021, 98, 171–205. [Google Scholar] [CrossRef] [PubMed]
- Khwaldia, K.; Attour, N.; Matthes, J.; Beck, L.; Schmid, M. Olive byproducts and their bioactive compounds as a valuable source for food packaging applications. Compr. Rev. Food Sci. Food Saf. 2022, 21, 1218–1253. [Google Scholar] [CrossRef] [PubMed]
- Madureira, J.; Melgar, B.; Alves, V.D.; Moldão-Martins, M.; Margaça, F.M.A.; Santos-Buelga, C.; Barros, L.; Cabo Verde, S. Effect of Olive Pomace Extract Application and Packaging Material on the Preservation of Fresh-Cut Royal Gala Apples. Foods 2023, 12, 1926. [Google Scholar] [CrossRef]
- Chowdhary, V.; Alooparampil, S.V.; Pandya, R.G.; Tank, J. Physiological Function of Phenolic Compounds in Plant Defense System. In Phenolic Compounds—Chemistry, Synthesis, Diversity, Non-Conventional Industrial, Pharmaceutical and Therapeutic Applications; IntechOpen: London, UK, 2022. [Google Scholar] [CrossRef]
- Manso, T.; Lores, M.; de Miguel, T. Antimicrobial Activity of Polyphenols and Natural Polyphenolic Extracts on Clinical Isolates. Antibiotics 2021, 11, 46. [Google Scholar] [CrossRef]
- Sahin, S.; Bilgin, M. Olive tree (Olea europaea L.) leaf as a waste by-product of table olive and olive oil industry. J. Sci. Food Agric. 2015, 98, 1271–1279. [Google Scholar] [CrossRef]
- Satchanska, G. Antibacterial Activity of Plant Polyphenols. In Secondary Metabolites Trends and Reviews; IntechOpen: London, UK, 2022. [Google Scholar] [CrossRef]
- Sansoucy, R.; Alibes, X.; Berge, P.; Martilotti, F.; Nefzaoui, A.; Zoïopoulos, P. Olive By-Products for Animal Feed, 43rd ed.; FAO: Washington, DC, USA, 1985; pp. 14–18. [Google Scholar]
- Agatonovic-Kustrin, S.; Gegechkori, V.; Morton, D.V.; Tucci, J.; Ehtesham, U.R.; Ku, M.H. The bioprofiling of antibacterials in olive leaf extracts via thin layer chromatography-effect directed analysis (TLC-EDA). J. Pharm. Biomed. Anal. 2022, 219, 114916. [Google Scholar] [CrossRef]
- Russo, E.; Spallarossa, A.; Comite, A.; Pagliero, M.; Guida, P.; Belotti, V.; Caviglia, D.; Schito, A.M. Valorization and Potential Antimicrobial Use of Olive Mill Wastewater (OMW) from Italian Olive Oil Production. Antioxidants 2022, 11, 903. [Google Scholar] [CrossRef]
- Khelouf, I.; Karoui, I.J.; Lakoud, A.; Hammami, M.; Abderrabba, M. Comparative chemical composition and antioxidant activity of olive leaves Olea europaea L. of Tunisian and Algerian varieties. Heliyon 2023, 9, e22217. [Google Scholar] [CrossRef]
- Debs, E.; Abi-Khattar, A.M.; Rajha, H.N.; Abdel-Massih, R.M.; Assaf, J.-C.; Koubaa, M.; Maroun, R.G.; Louka, N. Valorization of Olive Leaves Through Polyphenol Recovery Using Innovative Pretreatments and Extraction Techniques: An Updated Review. Separations 2023, 10, 587. [Google Scholar] [CrossRef]
- Djenane, D.; Yangüela, J.; Derriche, F.; Bouarab, L.; Roncales, P. Extrait de feuilles d’olivier; tests in vitro vis-à-vis de Staphylococcus aureus, Salmonella Enteritidis et Pseudomonas aeruginosa; application sur la viande de dinde. Phytothérapie 2012, 10, 10–18. [Google Scholar] [CrossRef]
- Singleton, V.L.; Orthofer, R.; Lamuela-Raventós, R.M. Analysis of total phenols and other oxidation substrates and antioxidants by means of Folin-Ciocalteu reagent. Methods Enzymol. 1999, 299, 152–178. [Google Scholar] [CrossRef]
- Brand-Williams, W.; Cuvelier, M.E.; Berset, C. Use of a free radical method to evaluate antioxidant activity. Food Sci. Technol. 1995, 28, 25–30. [Google Scholar] [CrossRef]
- M07-A10; Methods for Dilution Antimicrobial Susceptibility Tests for Bacteria that Grow Aerobically. 11th ed. Clinical and Laboratory Standards Institute: Wayne, PA, USA, 2018; ISBN 1-56238-836-3.
- Sánchez, E.; Rivas, M.C.; Castillo, S.; Leos-Rivas, C.; García-Becerra, L.; Ortiz Martínez, D.M. Antibacterial and Antibiofilm Activity of Methanolic Plant Extracts against Nosocomial Microorganisms. Evid.-Based Complement Altern. Med. 2016, 2016, 1572697. [Google Scholar] [CrossRef]
- Medina, E.; Brenes, M.; Romero, C.; García, A.; Castro, A.D. Main antimicrobial compounds in table olives. J. Agric. Chem. 2007, 55, 9817–9823. [Google Scholar] [CrossRef]
- Edziri, H.; Jaziri, R.; Chehab, H.; Verschaeve, L.; Flamini, G.; Boujnah, D.; Hammami, M.; Aouni, M.; Mastouri, M. A comparative study on chemical composition, antibiofilm and biological activities of leaves extracts of four Tunisian olive cultivars. Heliyon 2019, 5, e01604. [Google Scholar] [CrossRef]
- Addab, N.; Fetni, S.; Hamlaoui, F.; Zerguine, A.; Mahloul, K. Evaluation comparative de l’activité anti-oxydante des extraits éthanoliques des feuilles d’Olea europaea L. de l’Est Algérien. J. Fac. Med. d Oran 2020, 4, 579–586. [Google Scholar] [CrossRef]
- Lee, O.-H.; Lee, B.-Y. Antioxidant and antimicrobial activities of individual and combined phenolics in Olea europaea leaf extract. Bioresour. Technol. 2010, 101, 3751–3754. [Google Scholar] [CrossRef]
- Muchuweti, M.; Nyamukonda, L.; Chagonda, L.S.; Ndhlala, A.R.; Mupure, C.; Benhura, M. Total phenolic content and antioxidant activity in selected medicinal plants of Zimbabwe. Int. J. Food Sci. Tech. 2006, 41, 28–33. [Google Scholar] [CrossRef]
- Antunes, B.F.; Otero, D.M.; Oliveira, F.M.; Jacques, A.C.; Gandra, E.A.; Zambiazi, R.C. Antioxidant and antimicrobial activity of olive trees cultivated in the Campanha Gaúcha region. Braz. J. Dev. 2020, 6, 21791–21805. [Google Scholar] [CrossRef]
- Hayes, J.E.; Allen, P.; Brunton, N.; O’Grady, M.N.; Kerry, J.P. Phenolic composition and in vitro antioxidant capacity of four commercial phytochemical products: Olive leaf extract (Olea europaea L.), lutein, sesamol and ellagic acid. Food Chem. 2011, 126, 948–955. [Google Scholar] [CrossRef]
- Debib, A.; Boukhatem, M.N. Phenolic Content, Antioxidant and Antimicrobial Activities of “Chemlali” Olive Leaf (Olea europaea L.). Int. J. Pharmacol. Phytochem. Ethnomed. 2017, 6, 38–46. [Google Scholar] [CrossRef]
- Rocha-Pimienta, D.M.-V.J.; Ramírez, J.D.-A.R. Pro-/antioxidant and antibacterial activity of olive leaf extracts according to bioavailability of phenolic compounds. Emir. J. Food Agric. 2020, 32, 479–487. [Google Scholar] [CrossRef]
- Usman, A.; Abdulrahman, F.I.; Usman, A. Qualitative phytochemical screening and in vitro antimicrobial effects of methanol stem bark extract of Ficus thonningii (Moraceae). Afr. J. Tradit. Complement. Altern. Med. 2009, 6, 289–295. [Google Scholar] [CrossRef]
- Savaroglu, F.; Ilhan, S.; Filik-Iscen, C. An evaluation of the antimicrobial activity of some Turkish mosses. J. Med. Plant Res. 2011, 5, 3286–3292. [Google Scholar]
- Eftekhar, F.; Yousefzadi, M.; Borhani, K. Antibacterial activity of the essential oil from Ferula gummosa seed. Fitoterapia 2004, 75, 758–759. [Google Scholar] [CrossRef]
- Ruberto, G.; Baratta, M.T.; Deans, S.G.; Dorman, H.J.D. Antioxidant and antimicrobial activity of Foeniculum vulgare and Crithmum maritimum essential oils. Planta Med. 2000, 66, 687–693. [Google Scholar] [CrossRef]
- Amini, F.; Krimpour, H.A.; Ghaderi, M.; Vaziri, S.; Ferdowsi, S.; Azizi, M.; Amini, S. Prevalence of Aminoglycoside Resistance Genes in Enterococcus Strains in Kermanshah, Iran. Iran. J. Med. Sci. 2018, 43, 487–493. [Google Scholar] [PubMed] [PubMed Central]
- Janakat, S.; Al-Nabulsi, A.; Allehdan SA, N.; Olaimat RA, H. Antimicrobial activity of amurca (olive oil lees) extract against selected foodborne pathogens. Food Sci. Technol. 2015, 35, 259–265. [Google Scholar] [CrossRef]
- Dermeche, S.; Nadour, M.; Larroche, C.; Moulti-Mati, F.; Michaud, P. Olive mill wastes: Biochemical characterizations and valorization strategies. Process Biochem. 2013, 48, 1532–1552. [Google Scholar] [CrossRef]
- Markin, D.; Duek, L.; Berdicevsky, I. In vitro antimicrobial activity of olive leaves. Mycoses 2003, 46, 132–136. [Google Scholar] [CrossRef] [PubMed]
- Sudjana, A.N.; D’Orazio, C.; Ryan, V.; Rasool, N.; Ng, J.; Islam, N.; Riley, T.V.; Hammer, K.A. Antimicrobial activity of commercial Olea europaea (olive) leaf extract. Int. J. Antimicrob. Agents 2009, 33, 461–463. [Google Scholar] [CrossRef] [PubMed]
- Mandal, M.K.; Domb, A.J. Antimicrobial Activities of Natural Bioactive Polyphenols. Pharmaceutics 2024, 16, 718. [Google Scholar] [CrossRef]
- Gökmen, M.; Kara, R.; Akkaya, L.; Torlak, E.; Önen, A. Evaluation of Antimicrobial Activity in Olive (Olea europaea) Leaf Extract. Am. J. Microbiol. 2014, 5, 37–40. [Google Scholar] [CrossRef]
- Abaza, L.; Taamalli, A.; Nsir, H.; Zarrouk, M. Olive Tree (Olea europeae L.) Leaves: Importance and Advances in the Analysis of Phenolic Compounds. Antioxidants 2015, 4, 682–698. [Google Scholar] [CrossRef]
- Lahdibi-Sahraoui, H.; El Berny, H.; El Karkour, M.; Quasmaoui, H.; Charof, R.; Mennane, Z. Antibacterial Activity of Aqueous and Methanolic Extracts of Olive (Olea europaea L.) Leaves Collected from Different Regions in Morocco. Der Pharma Chem. 2017, 9, 118–124. [Google Scholar]
- Al-Khafaji, A.N. Comparison of Antimicrobial Activity of Olive Leaves Extracts and Apple Cider Vinegar Against Bacterial isolates Obtained from Otitis Media. J. Univ. Kerbala 2018, 16, 3. [Google Scholar]
- Ibrahim, N.H.; Turkey, A.M.; Abd-al-Rahman, J. Study the effect of olive extract or refined oligonucleus on Staphylococcus aureus isolated from different clinical cases. Ann. Trop. Med. Public Health 2020, 23, SP23923, Corpus ID: 226566157. [Google Scholar] [CrossRef]
- Ghalandari, M.; Naghmachi, M.; Oliverio, M.; Nardi, M.; Ghafarian Shirazi, H.R.; Eilami, O. Antimicrobial effect of Hydroxytyrosol, Hydroxytyrosol Acetate and Hydroxytyrosol Oleate on Staphylococcus aureus and Staphylococcus Epidermidis. Electron. J. Gen. Med. 2018, 15, em46. [Google Scholar] [CrossRef]
- Sánchez-Gutiérrez, M.; Bascón-Villegas, I.; Rodríguez, A.; Pérez-Rodríguez, F.; Fernández-Prior, A.; Rosal, A.; Carrasco, E. Valorisation of Olea europaea L. Olive Leaves through the Evaluation of Their Extracts: Antioxidant and Antimicrobial Activity. Foods 2021, 10, 966. [Google Scholar] [CrossRef]
- Martín-García, B.; De Montijo-Prieto, S.; Jiménez-Valera, M.; Carrasco-Pancorbo, A.; Ruiz-Bravo, A.; Verardo, V.; Gómez-Caravaca, A.M. Comparative Extraction of Phenolic Compounds from Olive Leaves Using a Sonotrode and an Ultrasonic Bath and the Evaluation of Both Antioxidant and Antimicrobial Activity. Antioxidants 2022, 11, 558. [Google Scholar] [CrossRef] [PubMed]
- Elnahas, R.A.; Elwakil, B.H.; Elshewemi, S.S.; Olama, Z.A. Egyptian Olea europaea leaves bioactive extract: Antibacterial and wound healing activity in normal and diabetic rats. J. Tradit. Complement. Med. 2021, 11, 427–434. [Google Scholar] [CrossRef]
- Pereira, A.P.; Ferreira IC, F.R.; Marcelino, F.; Valentão, P.; Andrade, P.B.; Seabra, R.; Estevinho, L.; Bento, A.; Pereira, J.A. Phenolic compounds and antimicrobial activity of olive (Olea europea L.) leaves. Molecules 2007, 12, 1153–1162. [Google Scholar] [CrossRef]
- Ko, K.-W.; Kang, H.J.; Lee, B.Y. Antioxidant, Antimicrobial, and Antiproliferative activities of olive (Olea europaea L) Leaf extracts. Food Sci. Biotechnol. 2009, 18, 818–821. [Google Scholar]
- Testa, B.; Lombardi, S.J.; Macciola, E.; Succi, M.; Tremonte, P.; Iorizzo, M. Efficacy of olive leaf extract (Olea europaea L.) in marinated anchovies (Engraulis encrasicolus, L.) process. Heliyon 2019, 5, e01727. [Google Scholar] [CrossRef]
- Ahmed, A.M.; Rabii, N.S.; Garbaj, A.M.; Abolghait, S.K. Antibacterial effect of olive (Olea europaea L.) leaves extract in raw peeled undeveined shrimp (Penaeus semisulcatus). Int. J. Veter. Sci. Med. 2014, 2, 53–56. [Google Scholar] [CrossRef]
- Lee-Huang, S.; Zhang, L.; Huang, P.; Chang, Y.; Huang, P.L. Anti-HIV activity of olive leaf extract (OLE) and modulation of host cell gene expression by HIV-2003, 1 infection and OLE treatment. Biochem. Biophys. Res. Commun. 2003, 307, 1029. [Google Scholar] [CrossRef]
- Coşansu, S.; Kıymetli, O. Antimicrobial Activity of Olive Leaf Extract on Selected Foodborne Pathogens and its Effect on Thermal Resistance of Listeria monocytogenes in Sous Vide Ground Beef. Int. J. Agric. Env. Food Sci. 2021, 5, 236–242. [Google Scholar] [CrossRef]
- Aouidi, F.; Perraud-Gaime, I.; Roussos, S.; Hamdi, M. Etude de la répartition quantitative des phénols totaux dans l’olivier en fonction des organes et leur degré de maturité. In For a Renovated, Profitable and Competitive Mediterranean Olive Growing Sector: Proceedings Olivebioteq, Sfax, Tunisia, 15–19 December 2009; Karray, B., Khecharem, J., Sevastianos, R., Eds.; Institut de l’Olivier: Sfax, Tunisia, 2009; pp. 376–379. ISBN 978-9938-9513-0-1. [Google Scholar]
- Abaza, L.; Bouslama, L.; Benzekri, R.; Trabelsi, N.; Ameni, T.; Selim, J.; Zarrouk, M. Isolation of an antiviral compound from Tunisian olive twig cultivars. Microb. Path 2019, 128, 245–249. [Google Scholar] [CrossRef]
- Masoko, P.; Makgapeetja, D.M. Antibacterial, antifungal and antioxidant activity of Olea africana against pathogenic yeast and nosocomial pathogens. BMC Complement. Altern. Med. 2015, 15, 409. [Google Scholar] [CrossRef]
- Ceuppens, S.; Uyttendaele, M.; Drieskens, K.; Rajkovic, A.; Boon, N.; Van De Wiele, T. Survival of Bacillus cereus Vegetative Cells and Spores during In Vitro Simulation of Gastric Passage. J. Food Prot. 2012, 75, 690–694. [Google Scholar] [CrossRef] [PubMed]
- Hayrapetyan, H. Bacillus cereus Growth and Biofilm Formation: The Impact of Substratum, Iron Sources, and Transcriptional Regulator Sigma 54. Ph.D. Thesis, Wageningen University, Wageningen, The Netherlands, 2017; 182p. [Google Scholar]
- Vidic, J.; Chaix, C.; Manzano, M.; Heyndrickx, M. Food Sensing: Detection of Bacillus cereus Spores in Dairy Products. Biosensors 2020, 10, 15. [Google Scholar] [CrossRef] [PubMed]
- Thi, M.T.T.; Wibowo, D.; Rehm, B.H. Pseudomonas aeruginosa Biofilms. Int. J. Mol. Sci. 2020, 21, 8671. [Google Scholar] [CrossRef]
- Hongchao, D.; Ma, L.; Xu, Z.; Soteyome, T.; Yuan, L.; Yang, Z.; Jiao, X. Invited review: Role of Bacillus licheniformis in the dairy industry-friends or foes? Dairy Sci. TBC 2024, 107, 7520–7532. [Google Scholar] [CrossRef]
- Townsend, M.E.; Moat, J.; Jameson, E. CAUTI’s next top model—Model dependent Klebsiella biofilm inhibition by bacteriophages and antimicrobials. Biofilm 2020, 2, 100038. [Google Scholar] [CrossRef]
- Parastan, R.; Kargar, M.; Solhjoo, K.; Kafilzadeh, F. Staphylococcus aureus biofilms: Structures, antibiotic resistance, inhibition, and vaccines. Gene Rep. 2020, 20, 100739. [Google Scholar] [CrossRef]
- Shree, P.; Singh, C.K.; Sodhi, K.K.; Surya, J.N.; Singh, D.K. Biofilms: Understanding the structure and contribution towards bacterial resistance in antibiotics. Med. Microecology 2023, 16, 100084. [Google Scholar] [CrossRef]
- Matilla-Cuenca, L.; Gil, C.; Cuesta, S.; Rapún-Araiz, B.; Žiemytė, M.; Mira, A.; Lasa, I.; Valle, J. Antibiofilm activity of flavonoids on staphylococcal biofilms through targeting BAP amyloids. Sci. Rep. 2020, 10, 18968. [Google Scholar] [CrossRef]
- Validi, M.; Soltan-Dallal, M.M.; Douraghi, M.; Fallah-Mehrabadi, J.; Rahimi-Foroushani, A.; Frohesh-Tehrani, H. Identification of cytotoxin-producing Klebsiella oxytoca strains isolated from clinical samples with cell culture assays. Microb. Pathog. 2017, 113, 1–4. [Google Scholar] [CrossRef]
- Sadiq, F.A.; Li, Y.; Liu, T.; Flint, S.; Zhang, G.; Yuan, L.; Pei, Z.; He, G. The heat resistance and spoilage potential of aerobic mesophilic and thermophilic spore forming bacteria isolated from Chinese milk powders. Int. J. Food Microbiol. 2016, 238, 193–201. [Google Scholar] [CrossRef]
- Mezian, L.; Chincha, A.I.A.; Vecchione, A.; Ghelardi, E.; Bonatto, J.M.C.; Marsaioli, A.J.; Campelo, P.H.; Benamar, I.; Moussaoui, A.A.; Sant’Ana, A.S.; et al. Aerobic spore-forming bacteria in powdered infant formula: Enumeration, identification by MALDI-TOF mass spectrometry (MS), presence of toxin genes and rpoB gene typing. Int. J. Food Microbiol. 2022, 368, 109613. [Google Scholar] [CrossRef] [PubMed]
- Sadiq, F.A.; Flint, S.; Yuan, L.; Li, Y.; Liu, T.; He, G. Propensity for biofilm formation by aerobic mesophilic and thermophilic spore forming bacteria isolated from Chinese milk powders. Int. J. Food Microbiol. 2017, 262, 89–98. [Google Scholar] [CrossRef] [PubMed]
- Wang, N.; Gao, J.; Yuan, L.; Jin, Y.; He, G. Metabolomics profiling during biofilm development of Bacillus licheniformis isolated from milk powder. Int. J. Food Microbiol. 2021, 337, 108939. [Google Scholar] [CrossRef] [PubMed]
- Yuan, L.; Fan, L.; Liu, S.; Sant’Ana, A.S.; Zhang, Y.; Zhou, W.; Zheng, X.; He, G.; Yang, Z.; Jiao, X. Bacterial community analysis of infant foods obtained from Chinese markets by combining culture dependent and high-throughput sequence methods. Food Res. Int. 2022, 162 Pt B, 112060. [Google Scholar] [CrossRef]
- Fan, L.; Liu, S.; Dai, H.; Yuan, L.; Yang, Z.; Jiao, X. Genotype phenotype evaluation of the heterogeneity in biofilm formation by diverse Bacillus licheniformis strains isolated from dairy products. Int. J. Food Microbiol. 2024, 416, 110660. [Google Scholar] [CrossRef]
- Yeak, K.Y.C.; Perko, M.; Staring, G.; Fernandez-Ciruelos, B.M.; Wells, J.M.; Abee, T.; Wells-Bennik, M.H.J. Lichenysin Production by Bacillus licheniformis Food Isolates and Toxicity to Human Cells. Front. Microbiol. 2022, 13, 831033. [Google Scholar] [CrossRef]
- Zhou, J.; Wu, Y.; Liu, D.; LV, R. The effect of carbon source and temperature on the formation and growth of Bacillus licheniformis and Bacillus cereus biofilms. Food Sci. Technol. 2023, 186, 115239. [Google Scholar] [CrossRef]
- Jeyaraman, E.; Eltzov, E. Enhancing food safety: A low-cost biosensor for Bacillus licheniformis detection in food products. Talanta 2024, 276, 126152. [Google Scholar] [CrossRef]
- Blue, S.R.; Singh, V.R.; Saubolle, M.A. Bacillus licheniformis Bacteremia: Five Cases Associated with Indwelling Central Venous Catheters. Clin. Infect. Dis. 1995, 20, 629–633. [Google Scholar] [CrossRef]
- Ozkocaman, V.; Ozcelik, T.; Ali, R.; Ozkalemkas, F.; Ozkan, A.; Ozakin, C.; Akalin, H.; Ursavas, A.; Coskun, F.; Ener, B.; et al. Bacillus spp. among hospitalized patients with haematological malignancies: Clinical features, epidemics and outcomes. J. Hosp. Infect. 2006, 64, 169–176. [Google Scholar] [CrossRef]
- Haydushka, I.A.; Markova, N.; Kirina, V.; Atanassova, M. Recurrent sepsis due to Bacillus licheniformis. J. Glob. Infect. Dis. 2012, 4, 82–83. [Google Scholar] [CrossRef] [PubMed]
- La Jeon, Y.; Yang, J.J.; Kim, M.J.; Lim, G.; Cho, S.Y.; Park, T.S.; Suh, J.T.; Park, Y.H.; Lee, M.S.; Kim, S.C.; et al. Combined Bacillus licheniformis and Bacillus subtilis infection in a patient with oesophageal perforation. J. Med. Microbiol. 2012, 61 Pt 12, 1766–1769. [Google Scholar] [CrossRef] [PubMed]
- Nayeri Fasaei, B.; Ashrafi Tamai, I.; Joghataei, S.M. First Isolation of Bacillus licheniformis from Bovine Mastitis in Iran. Arch. Razi Inst. 2023, 78, 1690–1697. [Google Scholar] [CrossRef]
- Zou, Q.; Cai, M.; Hu, Y.; Ge, C.; Wang, X.; Duan, R. Bacillus licheniformis bloodstream infections associated with oral probiotic administration: Two case reports. Indian J. Med. Microbiol. 2024, 47, 100485. [Google Scholar] [CrossRef]
- Karygianni, L.; Ren, Z.; Koo, H.; Thurnheer, T. Biofilm Matrixome: Extracellular Components in Structured Microbial Communities. Trends Microbiol. 2020, 28, 668–681. [Google Scholar] [CrossRef]
- Carraro, L.; Fasolato, L.; Montemurro, F.; Martino, M.E.; Balzan, S.; Servili, M.; Novelli, E.; Cardazzo, B. Polyphenols from olive mill waste affect biofilm formation and motility in Escherichia coli K-12. Microb. Biotechnol. 2014, 7, 265–275. [Google Scholar] [CrossRef]
- Glasenapp, Y.; Cattò, C.; Villa, F.; Saracchi, M.; Cappitelli, F.; Papenbrock, J. Promoting Beneficial and Inhibiting Undesirable Biofilm Formation with Mangrove Extracts. Int. J. Mol. Sci. 2019, 20, 3549. [Google Scholar] [CrossRef]
- Silva, L.N.; Zimmer, K.R.; Macedo, A.J.; Trentin, D.S. Plant Natural Products Targeting Bacterial Virulence Factors. Chem. Rev. 2016, 116, 9162–9236. [Google Scholar] [CrossRef]
- Asfour, H.Z. Anti-Quorum Sensing Natural Compounds. J. Microsc. Ultrastruct. 2018, 6, 1–10. [Google Scholar] [CrossRef]
- Song, Z.-M.; Zhang, J.-L.; Zhou, K.; Yue, L.-M.; Zhang, Y.; Wang, C.-Y.; Wang, K.-L.; Xu, Y. Anthraquinones as Potential Antibiofilm Agents Against Methicillin-Resistant Staphylococcus aureus. Front. Microbiol. 2021, 12, 709826. [Google Scholar] [CrossRef]
- Selim, S.; Albqmi, M.; Al-Sanea, M.M.; Alnusaire, T.S.; Almuhayawi, M.S.; AbdElgawad, H.; Al Jaouni, S.K.; Elkelish, A.; Hussein, S.; Warrad, M.; et al. Valorizing the usage of olive leaves, bioactive compounds, biological activities, and food applications: A comprehensive review. Front. Nutr. 2020, 9, 1008349. [Google Scholar] [CrossRef] [PubMed]
- Dubreuil, J.D. Fruit extracts to control pathogenic Escherichia coli: A sweet solution. Heliyon 2020, 6, e03410. [Google Scholar] [CrossRef]
- Ebrahimnejad, H.; Ebadi, M.; Mansouri-najand, L. The anti-planktonic and anti-biofilm formation activity of Iranian pomegranate peel hydro-extract against Staphylococcus aureus. Iran. J. Vet. Sci. 2020, 12, 1–9. [Google Scholar] [CrossRef]
- Takó, M.; Kerekes, E.B.; Zambrano, C.; Kotogán, A.; Papp, T.; Krisch, J.; Vágvölgyi, C. Plant Phenolics and Phenolic-Enriched Extracts as Antimicrobial Agents against Food-Contaminating Microorganisms. Antioxidants 2020, 18, 165. [Google Scholar] [CrossRef]
- Górniak, I.; Bartoszewski, R.; Króliczewski, J. Comprehensive review of antimicrobial activities of plant flavonoids. Phytochem. Rev. 2019, 18, 241–272. [Google Scholar] [CrossRef]
- Zambrano, C.; Kerekes, E.B.; Kotogán, A.; Papp, T.; Vágvölgyi, C.; Krisch, J.; Takó, M. Antimicrobial activity of grape, apple and pitahaya residue extracts after carbohydrase treatment against food-related bacteria. LWT Food Sci. Technol. 2019, 100, 416–425. [Google Scholar] [CrossRef]
- Ali, I.A.A.; Neelakantan, P. Antibiofilm activity of phytochemicals against Enterococcus faecalis: A literature review. Phytother. Res. 2022, 36, 2824–2838. [Google Scholar] [CrossRef]
- Bubonja-Šonje, M.; Knežević, S.; Abram, M. Challenges to antimicrobial susceptibility testing of plant-derived polyphenolic compounds. Arh. Hig. Rada Toksikol. 2020, 71, 300–311. [Google Scholar] [CrossRef]

| Strain Origin | Target Strains |
|---|---|
| ATCC strains | -Enterococcus faecalis WDCM 0009 -Staphylococcus aureus ATCC 25923 -Staphylococcus aureus MU 50 -Bacillus cereus ATCC 14579 -Pseudomonas aeruginosa ATCC 27853 -Escherichia coli ATCC 25922 -Klebsiella pneumoniae ATCC 700603 |
| Strain isolates from milk samples | -Pseudomonas putida -Klebsiella oxytoca -Bacillus licheniformis -Bacillus cereus (b) -Bacillus cereus (a) |
| Target Strains | Olive Twig Extracts | Antibiotic | Control (-) | |||||
|---|---|---|---|---|---|---|---|---|
| W1 | AZ1 | CH1 | W2 | AZ2 | CH2 | Neomycin (30 µg/disc) | DMSO | |
| Staphylococcus aureus ATCC 25923 | 7.5 ± 0.71 | 7.4 ± 0.85 | 8.5 ±0.71 | 8.25 ± 1.06 | 9.5 ± 0.71 | 8.25 ±0.35 | 30 ±1.41 | 6 |
| Bacillus cereus (a) | 7.05 ± 0.071 | 6.9 ± 0.14 | 7.5 ± 0.71 | 8.05 ± 0.35 | 9.1 ± 0.28 | 8.5 ± 0.71 | 29.75 ± 1.06 | 6 |
| Enterococcus faecalis WDCM 00009 | 12.5 ± 0.71 | 19.5 ± 0.71 | 25.5 ± 0.71 | 24.5 ± 0.71 | 25.9 ± 0.14 | 22.5 ± 0.71 | 7 ± 0.28 | 6 |
| Pseudomonas putida | 6.9 ± 0.14 | 7.1 ± 0.14 | 8.75 ± 0.35 | 8.88 ± 0.18 | 10.5 ± 0.71 | 8.5 ± 0.71 | 18.5 ± 0.71 | 6 |
| Bacillus cereus ATCC 14579 | 7.75 ± 0.35 | 6.9 ± 0.14 | 6.75 ± 0.35 | 7.75 ± 1.06 | 8.5 ± 0.71 | 8 ± 0.00 | 30.5 ± 0.71 | 6 |
| Escherichia coli ATCC 25922 | 6 ± 0.0 | 6 ± 0.0 | 6 ± 0.0 | 6 ± 0.0 | 6.9 ± 0.14 | 6 ± 0.0 | 21.0 ± 1.41 | 6 |
| Klebsiella oxytoca | 8.1 ± 0.71 | 7.05 ± 0.71 | 8 ± 1.41 | 8 ± 0.14 | 9.25 ± 2.33 | 7.5 ± 0.71 | 15.5 ± 0.71 | 6 |
| Bacillus cereus (b) | 7.05 ± 0.071 | 6.9 ± 0.14 | 7.5 ± 0.71 | 8.1 ± 0.14 | 9 ± 1.41 | 7.5 ± 0.71 | 13.5 ± 2.12 | 6 |
| Staphylococcus aureus MU50 | 6.9 ± 0.14 | 6.75 ± 0.35 | 7.5 ± 0.71 | 8.5 ± 0.71 | 8.75 ± 0.35 | 8.25 ± 0.35 | 14.5 ± 0.71 | 6 |
| Bacillus licheniformis | 7.95 ± 0.071 | 8.5 ± 0.71 | 8.5 ± 0.71 | 7.75 ± 0.35 | 8.5 ± 0.71 | 7.5 ± 0.71 | 32 ± 1.41 | 6 |
| Klebsiella pneumoniae ATCC 700603 | 6 ± 0.0 | 6 ± 0.0 | 6 ± 0.0 | 6 ± 0.0 | 6.5 ± 0.07 | 6 ± 0.0 | 16.5 ± 0.71 | 6 |
| Pseudomonas aeruginosa ATCC 27853 | 8 ± 1.41 | 9.5 ± 0.71 | 10.5 ± 0.71 | 10.25 ± 0.35 | 14.5 ± 0.71 | 11.5 ± 0.71 | 20.5 ± 0.71 | 6 |
| Target Strains | Olive Twig Extracts | ControlS | ||||||
|---|---|---|---|---|---|---|---|---|
| W1 | AZ1 | CH1 | W2 | AZ2 | CH2 | SW | DMSO | |
| Staphylococcus aureus ATCC 25923 | - | - | - | - | - | + | + | + |
| Bacillus cereus ATCC 14579 | + | + | + | + | + | + | + | + |
| Enterococcus faecalis WDCM 00009 | - | - | - | - | - | - | + | + |
| Pseudomonas putida | - | - | - | - | - | - | + | + |
| Escherichia coli ATCC 25922 | + | - | - | - | - | + | + | + |
| Klebsiella oxytoca | - | - | - | - | - | - | + | + |
| Bacillus cereus (b) | + | - | - | + | + | + | + | + |
| Staphylococcus aureus MU50 | - | - | - | - | - | - | + | + |
| Bacillus licheniformis | - | - | - | - | - | - | + | + |
| Klebsiella pneumoniae ATCC 700603 | - | - | - | - | - | - | + | + |
| Pseudomonas aeruginosa ATCC 27853 | + | - | - | - | - | - | + | + |
Disclaimer/Publisher’s Note: The statements, opinions and data contained in all publications are solely those of the individual author(s) and contributor(s) and not of MDPI and/or the editor(s). MDPI and/or the editor(s) disclaim responsibility for any injury to people or property resulting from any ideas, methods, instructions or products referred to in the content. |
© 2025 by the authors. Licensee MDPI, Basel, Switzerland. This article is an open access article distributed under the terms and conditions of the Creative Commons Attribution (CC BY) license (https://creativecommons.org/licenses/by/4.0/).
Share and Cite
Dermeche, S.; Mezoued, K.; Naib, H.; Senani, N.; Chaouche, T.A.; Alenazy, R.; Alhussaini, M.S.; Abdulrahman A. I., A.; Alqasmi, M.; Almufarriji, F.M.; et al. Olive Tree Twigs as an Attractive Green Source of Antioxidant and Antibiofilm Biomolecules. Processes 2025, 13, 559. https://doi.org/10.3390/pr13020559
Dermeche S, Mezoued K, Naib H, Senani N, Chaouche TA, Alenazy R, Alhussaini MS, Abdulrahman A. I. A, Alqasmi M, Almufarriji FM, et al. Olive Tree Twigs as an Attractive Green Source of Antioxidant and Antibiofilm Biomolecules. Processes. 2025; 13(2):559. https://doi.org/10.3390/pr13020559
Chicago/Turabian StyleDermeche, Samia, Kahina Mezoued, Hinda Naib, Nassima Senani, Thinina Afif Chaouche, Rawaf Alenazy, Mohammed Sanad Alhussaini, Alyahya Abdulrahman A. I., Mohammed Alqasmi, Fawaz M. Almufarriji, and et al. 2025. "Olive Tree Twigs as an Attractive Green Source of Antioxidant and Antibiofilm Biomolecules" Processes 13, no. 2: 559. https://doi.org/10.3390/pr13020559
APA StyleDermeche, S., Mezoued, K., Naib, H., Senani, N., Chaouche, T. A., Alenazy, R., Alhussaini, M. S., Abdulrahman A. I., A., Alqasmi, M., Almufarriji, F. M., Alturaiki, F. M., Bedouhene, S., Nabti, E.-h., Trabelsi, L., & Houali, K. (2025). Olive Tree Twigs as an Attractive Green Source of Antioxidant and Antibiofilm Biomolecules. Processes, 13(2), 559. https://doi.org/10.3390/pr13020559






